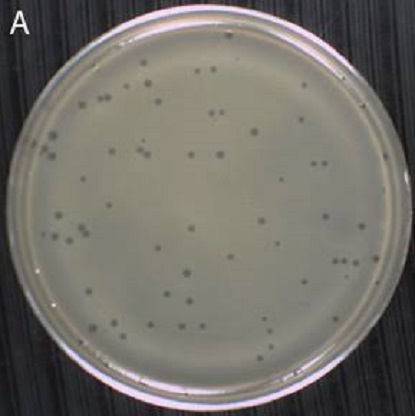
#
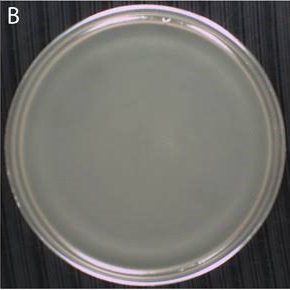
#

BS-Peroxy™ is a Powerful biocide vanishes all type of evoloped and unevolped viruses . Confirms to European norms EN 14476:2013. Leaves no bio hazardous residuals. Compatability with fogger machine and steamers.Covid claim in just 5 minutes.Surface, Instrument disinfectant as per cdc guidelines.BS-Peroxy is a new genration Hydrogen Peroxide based surface and environment disinfectant.BS-Peroxy™ is totally non-toxic,non-carcinogenic,non-irritant and eco-friendly at user dilution.BS-Peroxy™ assures rapid terminal disinfection of OT,ICCU,ICU,NICU & recovery rooms.BS-Peroxy™ is a preferred disinfectant for QA ,QCm Sterile areas of pharma & bio product industry.Optimam material compatibility. Excellent cleaning and disinfecting performing in one step.
Effect on viruses after 5 mins of disinfection of BS-Peroxy™

EN 14476 : 2013 + A2 : 2019
EN 14476 : 2013 + A2 : 2019
 EN 14348 : 2006
EN 14348 : 2006
 ISO 9001 : 2015
ISO 9001 : 2015
 ISO 13485 : 2016
ISO 13485 : 2016
 WHO-GMP compliment
WHO-GMP compliment
 CE in according to Medical Devices Directive - 93/43/EEC & Biocidal Products Directive - 98/8/EC
CE in according to Medical Devices Directive - 93/43/EEC & Biocidal Products Directive - 98/8/EC
BS-Peroxy™ is the unique chemical properties of hydrogen peroxide as well as its ecological friendliness predestinate this chemical for an extensive use in a variety of environmental applications. There are numerous examples where hydrogen peroxide helps to prevent or reduce negative impacts on the environment. Furthermore, Hydrogen peroxide is often regarded as a true “green chemical”. In contrast to many other red-ox agents, hydrogen peroxide introduces no additional substances other than water into the reaction system and an excess can be easily decomposed into water and oxygen, not interfering thereby with subsequent reaction steps.









